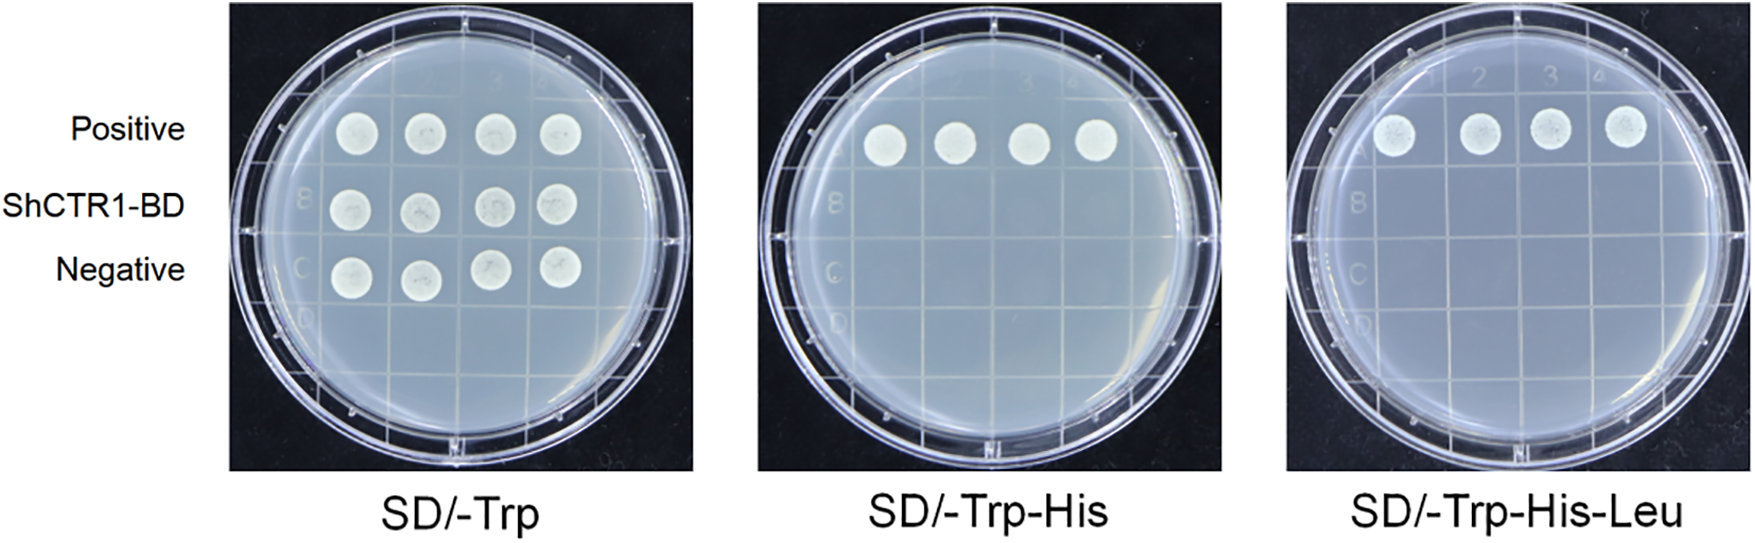
images
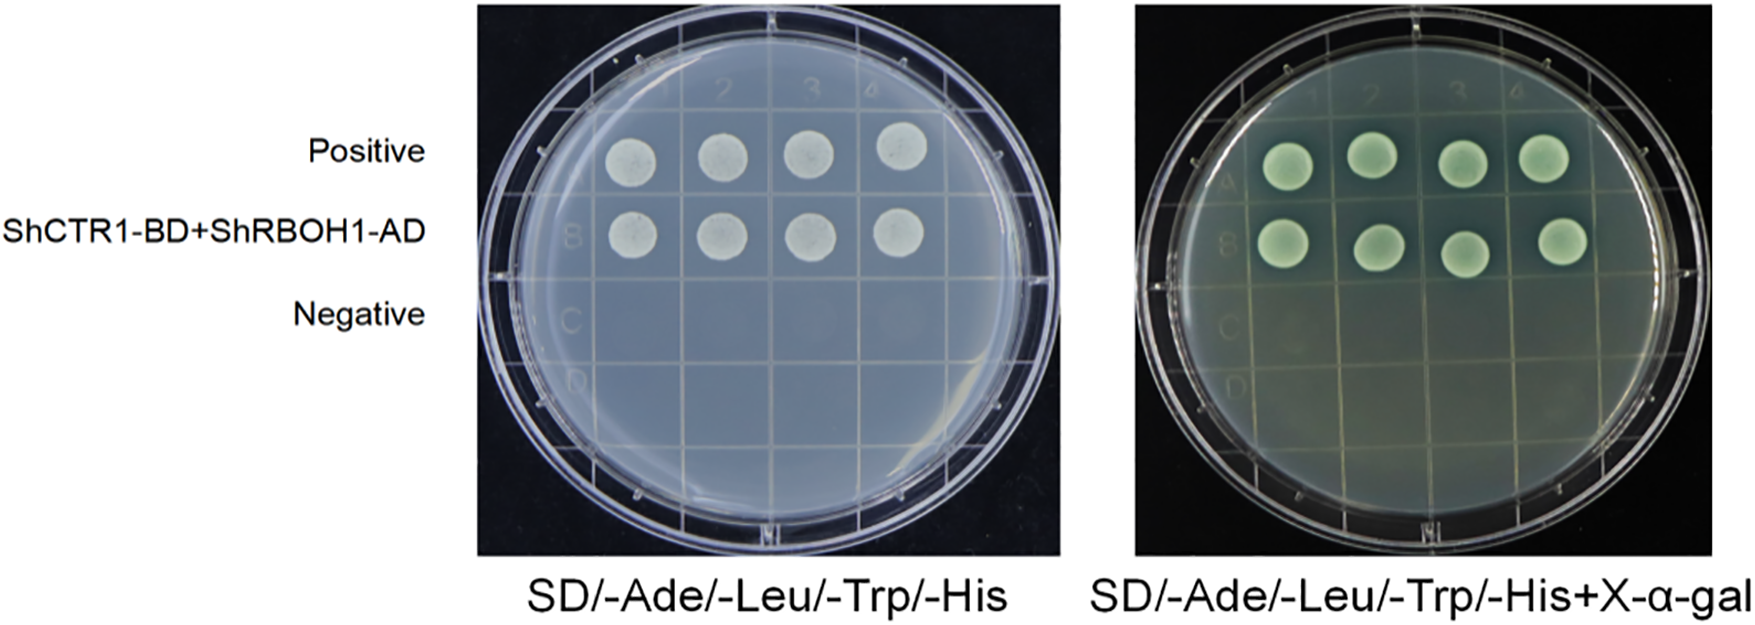
images

Open Access
ARTICLE
ShCTR1 Interacts with ShRBOH1 to Positively Regulate Aerenchyma Formation in Saussurea inversa through ROS Mediation
1 School of Agriculture and Animal Husbandry, Qinghai University, Xining, 810016, China
2 Key Laboratory of Landscape Plants of Qinghai Province, Qinghai University, Xining, 810016, China
3 School of Ecol-Environmental Engineering, Qinghai University, Xining, 810016, China
4 State Key Laboratory of Plateau Ecology and Agriculture, Qinghai University, Xining, 810016, China
* Corresponding Author: Tao He. Email:
(This article belongs to the Special Issue: Multi-omics Approach to Understand Plant Stress Tolerance)
Phyton-International Journal of Experimental Botany 2024, 93(5), 1023-1042. https://doi.org/10.32604/phyton.2024.050066
Received 26 January 2024; Accepted 08 April 2024; Issue published 28 May 2024
Abstract
Saussurea inversa is one of the Tibetan medicine with developed aerenchyma. In this study, we investigated the function of the ShCTR1 gene related to the formation of aerenchyma. The study of the occurrence and formation of aerenchyma in S. inversa has certain theoretical significance in revealing the special mechanism of alpine plants adapting to the environment. The results of yeast two-hybrid experiments showed that S. inversa ShCTR1 interacted with the ShRBOH1, which is a key producer of reactive oxygen species (ROS), and it was hypothesized that ShCTR1 regulation of aerenchyma formation in S. inversa mainly mediated by ROS. Aerenchyma induction and inhibition experiments were carried out on S. inversa seedlings, it was shown that ROS inducer (AT) and Ethene (ETH) induced the formation of aerenchyma in S. inversa well in roots, stems, and leaves, and Ethylene inhibitor (1-MCP) and ROS inhibitor DPI (diphenylene iodonium) inhibited the formation of aerenchyma of S. inversa in different degrees, which proved that ROS and ethylene (ET) were positively correlated with the formation of aerenchyma. Meanwhile, AT and ETH well induced the expression of the ShCTR1 gene, and 1-MCP and DPI inhibited the expression of the ShCTR1 gene to different degrees, which proved that ROS and ET were also positively correlated with the expression of the ShCTR1 gene. ShCTR1 was transferred into tobacco (Nicotiana tabacum L.), then repeat the above experiment. It was shown that positive rate and porosity were lowest and highest after DPI and AT treatments, respectively, it showed a positive correlation, which proved that the ShCTR1 gene was positively regulating the formation of aerenchyma. Overexpression of the ShCTR1 gene increased the content of ROS, consequently, the regulation of aerenchyma formation by the ShCTR1 gene is mainly mediated by ROS. It suggested that the formation of aerenchyma in S. inversa was related to hypoxia in the alpine environment, and ShCTR1 interacts with ShRBOH1 to positively regulate the formation of aerenchyma mainly mediated by ROS.Keywords
Aerenchyma usually exists in the form of thin-walled tissue and spongy tissue and is especially common in the nutrient organs of aquatic plants. Katsuhiro et al. [1] found that aerenchyma was mainly formed in the cortex of maize (Zea mays L.), and the main morphological characteristic was the formation of inter-cellular gaps after cell apoptosis. Liu et al. [2] found a similar morphology in Narrow-Leaved Cattail (Typha angustifolia L.) leaves, with a large number of gaps between cells, especially in leaves at the mature stage.
In plants, reactive oxygen species (ROS) are known as cellular second messengers that regulate several aspects of plant growth and development, as well as plant responses to environmental stresses. Zhang et al. [3] found that when the accumulation of ROS exceeds a certain threshold, they are toxic, and excessive ROS accumulation may peroxidize lipids on cell membranes, and DNA is susceptible to damage, causing denaturation of proteins, oxidation of carbohydrates, and catabolism of pigments, and irreversible damage to the activities of certain enzymes. Yamauchi et al. [4] found that rice (Oryza sativa L.) roots can induce aerenchyma formation through ethylene (ET) and ROS-mediated signaling. Metallothionein (MT) can act as a ROS scavenger and is rich in cysteine. In the rice (O. sativa) root system, the expression of MT1a, MT1b, MT1c, and MT1Ld was higher than other MT genes. In the root cortex where aerenchyma formed, the expression of MT1a, MT1b, and MT1Ld was reduced before aerenchyma formation. These findings suggest that the accumulation of ROS in the cortex is necessary for the formation of aerenchyma in rice (O. sativa) roots, which is aided by the down-regulation of the MT1 gene, and thus the amount of ROS accumulation depends on the amount of its scavenger. Trobacher [5] also conducted a series of studies on aerenchyma formation and ROS involvement in wheat (Triticum aestivum L.) root system by subjecting wheat (T. aestivum) roots to ROS treatment, which showed that aerenchyma formation started in the middle of the root cortex and then spread around.
In a study on the formation of aerenchyma in T. angustifolia leaves, Liu et al. [2] found that ET is an important signaling molecule for the programmed cell death (PCD) process and that the formation of aerenchyma can be induced by ETH, even in the presence of sufficient oxygen. The reason for the generation of aerenchyma is explained by the increase in cellulase activity due to the increase in ET concentration in the plant after moisture damage, which causes cell wall lysis and a series of change processes leading to the formation of aerenchyma [6]. Maize (Z. mays) roots treated by ET or grown under hypoxia conditions both share the same process. ET was the first gaseous phytohormone to be discovered. ET plays a particularly important role in adaptive responses to flooding [7]. The ET synthesis pathway consists of the ACC (1-aminocyclic propane-1-carboxylate) synthase [8]. The presence of ACC has been detected in flooded roots of many plant species, and ACC accumulated due to hypoxia is usually translocated to the stem through the xylem, where it is rapidly oxidized [9]. Flooding results in ET accumulation, which leads to the development of adventitious roots and the formation of aerenchyma [10]. The initiation of PCD in anoxic maize (Z. mays) roots requires ET for signaling [11]. Plants can quickly detect flooding by passively capturing ET and using the signal to pre-adapt to impending hypoxia. ET in Arabidopsis can be augmented by the addition of the NO scavenger PHYTOGLOBIN1 to enhance Group VII Ethylene response factor (ERFVII) stability before hypoxia [12]. These studies provide a foundation for a better understanding of how plants adapt to secondary hazards associated with hypoxia.
In nature, high altitude is also a major source of hypoxic environments. The Tibetan Plateau is one of the highest altitude regions in the world, where the average oxygen content is less than 60% of that at sea level. Alpine plants that have grown in this region for a long time generally have well-developed aerenchyma [13]. So, which type of aerenchyma do alpine plants have? Are the causes consistent with those of aquatic or wet plants? These questions are worthy of in-depth study. The low hypoxia environment of the Tibetan Plateau provides a new platform for the study of aerenchyma in terrestrial plants. S. inversa is a perennial herbaceous plant in the genus Saussurea DC. of the family Compositae, which is mainly found in the alpine rhyolite flats and snow and ice screen belts of the Tibetan Plateau at an altitude of 3700–5400 meters above sea level [14]. The above-ground parts of S. inversa can be used as medicine, which has some curative effects on rheumatoid arthritis, etc., and is a traditional Chinese medicine [15]. In addition, it is also a typical alpine plant with strong adaptability to the extreme environment of the plateau, and its most representative anatomical feature is the well-developed aerenchyma tissue in the roots, stems, and leaves, which is an adaptive structure of S. inversa to the extreme environment. Research on the formation and occurrence mechanism of aerenchyma in S. inversa is not only of great theoretical significance for revealing the physiological mechanism of alpine plants adapting to the environment but also of great guiding significance for the study of the development of plant tissues and organs.
In this study, S. inversa, which grows naturally in the Qinghai-Tibetan Plateau, was selected as the experimental material, and the aerenchyma was used as the research object. Based on the genes related to the formation of the aerenchyma that had been cloned by molecular biology technology [16], we investigated the gene expression and function, and discussed the signal transduction pathway of the formation of the aerenchyma in-depth, to provide a scientific basis for the molecular adaptation mechanism of alpine plants and provide theoretical support for the conservation and utilization of medicinal economic plants. This would provide a scientific basis for the molecular adaptation mechanism of alpine plants, and at the same time provide theoretical support for the conservation and utilization of medicinal economic plants.
Seeds of S. inversa were harvested from Darban Mountain, a tributary of Qilian Mountains, Menyuan County, Qinghai Province, at an altitude of about 4100 m in Driftstone Beach.
2.2.1 Yeast Two-Hybrid Cross between ShCTR1 and ShRBOH1
The vectors used in this yeast two-hybridization are PGADT7 and PGBKT7, to ensure that the target fragment is inserted into the vector in the correct direction, the upstream primer 5′ end of the upstream enzyme cleavage site and the first 15–18 bases of the vector fragment as a protective base, and the downstream primer is the same. Information on the primers used for yeast two-hybridization is shown in Table 1.

Decoy Vector Construction and Toxicity and Self-Activation Detection
Homologous recombination of the target gene into the pGBKT7 backbone, the transformation of yeast Y2HGold receptor cells, picking the yeast monoclonal clones grown on SD/-Trp plate, inoculated into 50 ml of SD/-Trp liquid medium, 30°C, 200 rpm culture 16–24 h, the concentration of the bacterial solution was determined by OD600, if the OD600 is less than 0.8, it means that the bait protein is toxic to yeast and not suitable for yeast two-hybridization experiments. The pGBKT7-bait and pGBKT7 empty vector were streaked and cultured on SD/-Trp, SD/-Trp/-His, and SD/-Trp/-His/-Leu plates, respectively, at a constant temperature of 30°C for 2–4 d. If the yeast could not grow on the two-deficient medium, it indicated that it could not be self-activated by itself, and it was possible to carry out the next experiment.
Prepare pGBKT7-bait yeast liquid, pick the monoclonal colony of appropriate size on SD/-Trp plate, and incubate in 50 ml SD/-Trp liquid medium (containing Kan 20 µg·mL−1) at 30°C for 16–24 h under constant temperature with 200 rpm, centrifuge at 600 g for 5 min, discard the supernatant, and take 5 ml SD/-Trp liquid The culture medium was resuspended, and yeast sensory cells were prepared using the Yeast Sensory Preparation Kit. The pGADT7-prey vector was transferred into the above sensory state and spread on SD/-Leu/-Trp two-deficient medium for 3–5 d. The monoclones were picked and spread on four-deficient medium, SD/-Ade/-His/-Leu/-Trp and SD/-Ade/-His/Leu/-Trp + X-α-Gal, and then photographed and recorded after 3–5 d.
2.2.2 Induction and Inhibition of Aerenchyma Organization
Seedlings of S. inversa cultivated for 60 d were selected as experimental materials. Referring to the method of induction and inhibition of aerenchyma in sunflower (H. annuus) hypocotyls by [17], the following treatments were made after appropriate adjustments were made to S. inversa seedling.
After seed germination, the seeds were transferred to rectangular transparent pots for wall culture so that the growth of primary roots could be observed in real time. The culture medium was supplemented with ethylene tetrachloride (ETH) (40 mg·L−1), the ET inhibitor 1-MCP (1-methylcyclopropene) (1 ppm), the ROS inducer AT (3-amino-1, 2, 4-triazole) (500 µmol/L), and the ROS inhibitor DPI (diphenylene iodonium) (1 µmol·L−1) were treated, and samples were taken after 7 d for subsequent structural observation and in situ gene expression studies.
Referring to the method of Zaqout et al. [18], the tissues of S. inversa after stress and induction treatments were cut, fixed with FAA fixative, stained with senna-solid green, sectioned in conventional paraffin, observed by light microscope, and the porosity was calculated by ImageJ software.
Based on the CDS sequence of the ShCTR1 gene, hybridization probes were designed as shown in Table 2. The slices were repaired in repair solution for 15 min and cooled naturally. Then draw circles with a histochemical pen, and according to the different index characteristics of different tissues, add proteinase K (20 ug·mL−1) dropwise for digestion at 37° for 15 min. Rinse with pure water and then wash with PBS 3 times, each time for 5 min. add the pre-hybridization solution dropwise, and incubate at 37°C for 1 h. Pour off the pre-hybridization solution, add the probe-containing hybridization solution dropwise, and leave it at 40°C in a thermostat overnight. Wash the hybridization solution with 2×SSC, 1×SSC and 0.5×SSC for 10 min. Dropwise addition of branching probe: gently shake the sections dry, dropwise add 60 µL of the corresponding pre-warmed branching probe hybridization solution, and place them horizontally in a wet box at 40°C for 45 min. Wash them again and dropwise add the hybridization solution, dilute it to 1:400, and then repeat the washing operation after 3 h of incubation at 42°C. DAPI staining solution was added dropwise to the sections, and the sections were incubated for 8 min under light, then rinsed and sealed with a drop of anti-fluorescence quenching sealer. The sections were observed under a fluorescence microscope and photographed.

2.2.3 Genetic Transformation of Tobacco with the ShCTR1 Gene
Plant overexpression vectors were constructed and mediated by Agrobacterium through the acquisition of tobacco sterile seedlings, Agrobacterium expansion, preparation of explants, Agrobacterium infestation and co-cultivation, bud-induced differentiation (the medium was: MS + 6-BA 1 mg·L−1 + Timentin 300 mg·L−1 + Kan 100 mg·L−1, pH = 5.8, changed every 14 d) and rooting and resistant plant screening (rooting medium (1/2 MS + Timentin 300 mg·L−1 + NAA 0.1 mg·L−1 + Kan 100 mg·L−1, pH = 5.8)), transformed tobacco using the leaf disc method, and several seeds of F0 generation of tobacco overexpressing the ShCTR1 gene were collected after PCR identification.
The transgenic tobacco was subjected to aerenchyma induction and suppression, and the plant materials were tobacco-positive seedlings (OF6) and SR tobacco with trans-ShCTR1 gene (Table 3), and the induction and suppression methods were the same as 2.2.2.

3.1 Validation of ShRBOH1 and ShCTR1 Interactions
The positive transformant amplification results after cloning of ShRBOH1-ORF1-ADh and ShCTR1-ORF6-BD are shown (Fig. 1), and the sequencing results were compared and consistent with the length of the CDS of the two genes.

Figure 1: PCR amplification results of positive transformants. M: DL5000, lanes 1–2 for ShRBOH1-ORF1-AD positive transformants, lanes 3–4 for ShCTR1-ORF6-BD positive transformants
3.1.1 Decoy Carrier Toxicity, Self-Activation Assay
Y2HGold[ShCTR1-BD] was inoculated in SD/-Trp liquid medium, cultured at 30°C, 200 rpm for 16–24 h, and the concentration of the bacterial fluid was determined by OD600, which was 1.562 and greater than 0.8 and could be used for subsequent yeast two-hybrid validation.
Y2HGold[ShCTR1-BD] grew normally in SD/-Trp, and could not grow in SD/-Trp/-His, SD/-Trp/-His/-Leu (Fig. 2), which indicated that Y2HGold [ShCTR1-BD] did not have self-activating activity, and it could be used for the next step of the experiment.
Figure 2: Self-activation detection. SD/-Trp tryptophan-deficient medium, SD/Trp-His for tryptophan and His reporter gene double-deficient medium, and SD-Trp-His-Leu for triple-deficient medium for tryptophan, His reporter gene, and leucine
3.1.2 Yeast Interaction Validation Results
Y2HGold[ShCTR1-BD+ShRBOH1-AD] monoclonal clones grew normally on four-deficient medium SD/-Ade/-His/-Leu/-Trp and SD/-Ade/-His/-Leu/-Trp + X-α-Gal, and the decomposition of X-α-Gal showed blue color, which indicated that the ShCTR1-BD+ShRBOH1-AD interactions exist in Fig. 3.
Figure 3: Yeast interaction validation. SD/-Ade/-His/-Leu/-Trp is a medium deficient in adenine, histidine, leucine, and tryptophan. SD/-Ade/-His/-Leu/-Trp + X-α-Gal is a medium with the same deficiencies but with the addition of X-α-Gal for color development
3.2 Results of Induction and Inhibition of Aerenchyma in S. inversa
S. inversa was sampled and photographed after 7 d of treatment, and the morphological structure was shown in Fig. 4. Under ETH and AT treatments, the ET triple response results showed a certain degree of ET compared to the control, and the epimeres, stems, and hypocotyls were thick, curved, and short, on the contrary, the elongation and growth of the stems were not inhibited after 1-MCP and DPI treatments.

Figure 4: Morphological structure of S. inversa treated for 7 d. CK for control, ETH for ethylene treatment, 1-MCP for ethylene inhibitor treatment, DPI for ROS inhibitor treatment, and AT for ROS treatment. Bar = 1 cm
3.2.1 Anatomical Structure and Porosity
Different tissues of S. inversa plants after 7 d of induction treatment were dissected and analyzed statistically for porosity using ImageJ software, and the results of paraffin sections and the graphs of calculations exported by the software are shown in Fig. A1. The results were analyzed and graphed using Prism software (GraphPad Software, San Diego, CA, USA).
In roots (Fig. 5a), porosity was lower than control after DPI and 1-MCP treatments, higher after ETH and AT treatments, and AT was more significant compared to ETH. DPI and AT are inhibitors and inducers of ROS, respectively, and their roles in the increase of root porosity in S. inversa are relatively more critical.

Figure 5: Porosity of S. inversa. DPI: ROS inhibitor treatment, 1-MCP: ethylene inhibitor treatment, CK: control, sprayed with an equal volume of water, ETH: ethylene producer vinblastine treatment, AT: ROS inducer treatment. (a) Root, (b) Stem, (c) Leaf; * denotes significance test results, ****p < 0.0001, ***p < 0.0002, **p < 0.001
In stems (Fig. 5b), 1-MCP treatment resulted in lower porosity than control, ETH and AT treatment resulted in higher porosity, and DPI treatment resulted in an insignificant change in porosity compared to control CK. 1-MCP and ETH are inhibitors and inducers of ET, respectively, and their roles are relatively more critical in the increase of porosity in stems of S. inversa.
In leaves (Fig. 5c), porosity was lower than control after 1-MCP treatment, higher after ETH and AT treatments, and less significant change in porosity from control CK after DPI treatment. Similar to the results in stems, 1-MCP, and ETH were inhibitors and inducers of ET, respectively, and had relatively more critical roles in the increase of leaf porosity in S. inversa.
The above results showed that AT and ETH, as inducers of ROS and ET, induced the formation of aerenchyma tissue in S. inversa well, whether in roots, stems, or leaves, and the corresponding two inhibitors, 1-MCP and DPI, inhibited the formation of aerenchyma tissue of S. inversa in different degrees, which proved the positive correlation between ROS and ET and the formation of aerenchyma tissue.
3.2.2 In situ Hybridization and Positivity Rate
In terms of the location of positive expression, the area where red positive expression is concentrated is the area where aerenchyma is formed (Fig. 6).

Figure 6: Plot of in situ hybridization results after reactive oxygen inducer AT treatment. (a) Root; (b) Stem; (c) Leaf. The blue color is the cell wall and the red color is a positive expression in the figure
Paraffin sections of different tissues of S. inversa after 7 d of induction treatment were made, and in situ, hybridization was carried out on paraffin sections with designed probes to observe the location of positive expression and the positive rate, and statistical analysis was performed with ImageJ software, and the results of the in situ hybridization and the graphs of the computational results exported by the software are shown in Fig. A2. The data were analyzed and graphs were drawn with Prism software. The results are shown:
In roots (Fig. 7a), the positivity rate was significantly lower than the control after DPI treatment, the change was not significant after 1-MCP treatment compared with the control, the positivity rate was higher after ETH and AT treatments, and the positivity rate was higher in AT treatment compared with ETH. DPI and AT are inhibitors and inducers of ROS, respectively, and their roles in the increase of positivity of S. inversa roots were relatively more obvious.

Figure 7: Positivity rate of S. inversa. DPI: ROS inhibitor treatment, 1-MCP: ethylene inhibitor treatment, CK: control, sprayed with an equal volume of water, ETH: ethylene producer vinblastine treatment, AT: ROS inducer treatment. (a) Roots, (b) Stems, (c) Leaves; * denotes the result of the significance test, ****p < 0.0001, ***p < 0.0002, ns: not significant
In stems (Fig. 7b), DPI treatment resulted in lower positivity than the control, 1-MCP treatment showed insignificant changes compared to the control, and ETH and AT treatments resulted in higher positivity. 1-MCP and ETH, which are inhibitors and inducers of ET, respectively, were not significant in the increase of stem positivity in S. inversa.
In leaves (Fig. 7c), the positivity rate was lower than the control after DPI treatment, and the positivity rate was significantly higher than the control after 1-MCP, ETH, and AT treatments, and AT was the highest, so the roles of DPI and AT in the increase of positivity rate of S. inversa roots were relatively more obvious.
The above results showed that AT and ETH, as inducers of ROS and ET, induced the expression of ShCTR1 gene very well both in roots, stems, and leaves, and the corresponding two inhibitors, 1-MCP and DPI, suppressed the expression of ShCTR1 gene to different degrees, which proved that ROS and ET were positively correlated with the expression of ShCTR1 gene and that ROS dominated the expression of ShCTR1 gene, and that ROS dominated the expression and ROS dominated.
3.3 Genetic Transformation of Tobacco with the ShCTR1 Gene
After obtaining sterile seedlings of tobacco, the healing tissues of leaf explants were induced to induce their differentiation and finally rooting culture, the process is shown in Fig. 8.

Figure 8: Different periods of ShCTR1 transformed plants. (a) Exosome preparation (b) exosome pre-culture (c) healing induction and differentiation (d) rooting culture
3.3.1 PCR Characterization of the Results of Genetic Transformation of the ShCTR1 Gene
The transformed completed lines were characterized and the PCR results showed agreement with the target bands (Fig. 9), proving that positive seedlings were obtained.

Figure 9: PCR identification of positive strain overexpressing ShCTR1 gene. Target gene fragment size: 786 bp; M:DL2000; 1: negative control; 2: positive control; 3–14: ShCTR1 gene positive seedlings
3.3.2 Results of Induction and Inhibition of Trans-ShCTR1-Positive Tobacco Aerenchyma Tissues
Under the same culture conditions, SR and OF6 (ShCTR1-positive tobacco) showed significant differences after 14 d, with OF6 sprouting significantly slower and growing relatively weaker (Fig. 10).

Figure 10: Comparison of SR and OF6 natural growth. SR for non-transgenic tobacco, OF6 for trans-ShCTR1 tobacco
Seedlings of OF6 and SR tobacco seeded at the same growth period were induced and inhibited by aerenchyma and sampled after 7 d for photographic observation (Fig. 11). The results showed that OF6 got better elongation growth relative to SR roots and stems under ETH inhibitor 1-MCP treatment. Under ETH treatment, both tobaccos were characterized by the ET triple response, with the difference that OF6 stem elongation was significantly greater than that of SR, while root development was greatly restricted and generally shorter than that of SR. The control (CK) also showed better elongation of the aboveground portion of OF6 under natural growth conditions, but root growth was significantly inhibited in the belowground portion. Under the treatment of the ROS inducer AT, elongation of the aboveground part and inhibition of the underground part could be observed, but neither was significant compared to the control. Under the treatment of the ROS inhibitor DPI, OF6 also showed better elongation of the above-ground part and less inhibition of the growth of the below-ground part.

Figure 11: Comparison of morphological structures of OF6 and SR under four treatments. 1-MCP for ethylene inhibitor treatment, ETH for ethylene treatment, CK for control, AT for ROS treatment, and DPI for ROS inhibitor treatment. Bar = 1 cm
Anatomical Structure and Porosity Analysis
Different tissues of SR tobacco and trans-ShCTR1-positive plants (OF6) after 7 d of induction treatment were analyzed anatomically, and porosity was statistically analyzed using ImageJ software, and the results of paraffin sections and graphs of calculations derived from the software are shown in Figs. A3 (SR) and A4 (OF6). The results are shown with Prism software for data analysis and graphing.
In roots (Fig. 12a), OF6 porosity was lower than control after DPI and 1-MCP treatments, and higher after ETH and AT treatments, with AT being more significant compared to ETH. DPI and AT are inhibitors and inducers of ROS, respectively, and their roles in the increase of tobacco root porosity are relatively more critical.

Figure 12: Analysis of tobacco root porosity. DPI: ROS inhibitor treatment, 1-MCP: ethylene inhibitor treatment, CK: control, sprayed with an equal volume of water, ETH: ethylene producer vinblastine treatment, AT: ROS inducer treatment. (a) Root; (b) Stem; (c) Leaf, * denotes significance test results, ****p < 0.0001, ***p < 0.0002, ns: not significant
Comparison of the porosity of SR and OF6 plants revealed that the porosity of trans-ShCTR1-positive tobacco was not lower than that of normal tobacco under all four treatments, and it was hypothesized that the ShCTR1 gene was regulating the formation of root aerenchyma.
In stems (Fig. 12b), OF6 porosity was significantly lower than control after 1-MCP and DPI treatments, while SR tobacco showed no significant change in porosity after the four treatments, which proved that the two inhibitors had a significant inhibitory effect on the ShCTR1 gene.
In leaves (Fig. 12c), especially in OF6 plants, porosity showed a significant tendency to be suppressed and induced by inhibitors and inducers, respectively, and the ShCTR1 gene showed positive characteristics in both reduction and increase of porosity, proving that the ShCTR1 gene was regulating aerenchyma formation.
Analysis of in situ Hybridization Positivity Rate
Paraffin sections of different tissues of OF6 after 7 d of induction treatment, with designed probes, in situ hybridization was carried out on paraffin sections to observe the location of positive expression and the rate of positivity, and statistical analyses were carried out with ImageJ software, and the results of in situ hybridization and the graphs of the calculated results exported by the software are shown in Fig. A5.
In roots (Fig. 13a), the positivity rate was significantly lower than the control after DPI treatment, the change was not significant after 1-MCP treatment compared with the control, the positivity rate was higher after ETH and AT treatments, and the positivity rate was higher in the AT treatment compared with ETH. DPI and AT are inhibitors and inducers of ROS, respectively, and their roles in the increase of positivity in roots of S. inversa were relatively more pronounced.

Figure 13: Analysis of tobacco tissue positivity rate. DPI: ROS inhibitor treatment, 1-MCP: ethylene inhibitor treatment, CK: control, sprayed with an equal volume of water, ETH: ethylene producer vinblastine treatment, AT: ROS inducer treatment. (a) Root; (b) Stem; (c) Leaf, * denotes significance test results, ****p < 0.0001
In stems (Fig. 13b), 1-MCP and DPI treatments resulted in lower positivity rates than the control and insignificant changes after treatment compared to the control, while ETH and AT treatments resulted in higher positivity rates. 1-MCP and ETH are inhibitors and inducers of ET, respectively, and have relatively more pronounced roles in the increased positivity rates of S. inversa stems.
In leaves (Fig. 13c), the change in positivity rate relative to the control was not significant after treatment with the two inhibitors, 1-MCP and DPI, and the positivity rate was significantly higher after both ETH and AT treatments than the control, with no significant difference between the two, so that the roles of both ETH and AT were more pronounced in the increase of positivity rate in the roots of S. inversa.
Yeast two-hybrid results showed that ShCTR1 interacts with ShRBOH1, and since RBOH1 is a positive regulator of ROS, the regulation of aerenchyma organization by the ShCTR1 gene in S. inversa may be mediated through ROS. Signal transduction of ET involves at least two receptors, ETR1 and ERS, both of which are two-component histidyl protein kinases that are prevalent in the prokaryotes family. Clark et al. [19] using a yeast two-hybrid assay found that the amino-terminal structural domain of CTR1 can interact with the receptor structural domain of ETR1 and that these interactions may be involved in the regulation of CTR1 activity. However, the signaling mechanism from ethylene perception to regulation of CTR1 is not clear.
To investigate the molecular mechanisms involved, aerenchyma tissue induction and suppression experiments were conducted on S. inversa, and the results showed that under AT and ETH treatments, a certain degree of ET triple response result was presented compared to the control, with thick, curved, and short epimeres, stems, and hypocotyls, and in contrast, the elongation growth of the stems was not suppressed by 1-MCP and DPI treatments. This is consistent with the statistical results of Kieber [20] on the growth status of the ctr1 mutant at all periods, in which the mutant showed a severe constitutive ethylene response phenotype at all periods of growth, e.g., ctr1 yellowing seedlings grown in the air can show the triple response; transferred to light, the unfolding of curved crooks and cotyledons was also significantly slower than that of the wild type; the cotyledons were darker green; the rosette leaves were much smaller than the wild type; late moss withdrawal, small inflorescences, and early flower sterility; and an underdeveloped root system.
The study also showed that AT and ETH, as inducers of ROS and ET, induced the formation of aerenchyma tissue in S. inversa well, both in roots, stems, and leaves, and the corresponding inhibitors, 1-MCP and DPI, inhibited the formation of aerenchyma tissue in S. inversa to varying extents, demonstrating that ROS and ET were positively correlated with the formation of aerenchyma. AT and ETH induced ShCTR1 gene expression in S. inversa well, and the corresponding inhibitors, 1-MCP and DPI, inhibited the expression of the ShCTR1 gene to varying extents, demonstrating the positive correlation of ROS and ET with the ShCTR1 gene. ShCTR1 gene expression, and the corresponding two inhibitors, 1-MCP and DPI, could inhibit the expression of the ShCTR1 gene in S. inversa to different degrees, proving that ROS and ET were also positively correlated with the expression of the ShCTR1 gene. This is consistent with the findings of Bie et al. [21], who isolated CsCTR1 in a study of the ET signaling pathway in cucumber and demonstrated external ethylene-induced CsCTR1 expression in roots, leaves, and shoot tips.
Giordano et al. [22] investigated the function of the CTR1 gene by CRISPR/Cas9 gene editing in melon and showed that the CTR1 gene plays an important role in the ripening process of melon and that it is a negative regulator that affects the initiation of ripening, but does not affect other important traits such as firmness of the flesh. To further demonstrate the ShCTR1 gene function, aerenchyma induction and suppression experiments were conducted on overexpressing ShCTR1 gene-positive tobacco (OF6), while normal SR tobacco was used as a control. The results showed that in the roots with the highest expression of the ShCTR1 gene, the positive rate and porosity after DPI and AT treatments were double-low and double-high, respectively, with a positive correlation between the positive rate and porosity, which proved that the ShCTR1 gene was regulating the formation of aerenchyma in roots. This is the same as the findings of Jakubowicz et al. [23] in poplar CTR1 and EIN2, where a constant ratio between the transcript levels of genes encoding the positive and negative components of ethylene signaling needs to be maintained under stress conditions, and Ptre-CTR3 may be a positive regulator of ethylene signaling in poplar. Since DPI and AT are inhibitors and inducers of ROS, respectively, and overexpression of the ShCTR1 gene increased the content of ROS, it is hypothesized that the regulation of aerenchyma formation by the ShCTR1 gene is mediated by ROS. Therefore, in S. inversa, the aerenchyma tissue, especially in the roots, may be an important structure in response to hypoxia stress, and it is mainly mediated by ROS. From the location of the positive expression, the red positive expression is concentrated in the region of aerenchyma formation, and the positive rate is proportional to the porosity, so it is assumed that the nuclear localization of the ShCTR1 gene plays a positive regulatory role in the formation of the aerenchyma tissue.
To verify the gene function, this study carried out experiments using proteomics, transgenic technology, tissue sections in situ hybridization, etc. The results showed that yeast two-hybrid experiments were carried out, which proved that there was a reciprocal relationship between ShCTR1 and ShRBOH1 genes. Using SR tobacco as the ontogeny and Agrobacterium as the vector, positive plants were obtained by the leaf disk method after Kan 100 mg·L−1 resistance plate screening and PCR assay, and several F0 generation seeds were obtained. The seedling of S. inversa, the positive seedling of transgenic ShCTR1 gene (OF6), and SR tobacco were treated with ETH, 1-MCP, AT, and DPI, respectively, and the samples were taken after 7 d. The porosity (proportion of aerenchyma) and positivity (ShCTR1 gene expression) were observed by paraffin sectioning. The results showed that both porosity and positivity were proportional in S. inversa and OF6, and were most significant in the root with the highest expression of the ShCTR1 gene, which proved that the ShCTR1 gene was regulating the formation of aerenchyma in S. inversa. Overexpression of the ShCTR1 gene increased the content of ROS, and thus the regulation of aerenchyma tissue formation in the S. inversa by the ShCTR1 gene is mainly mediated by ROS.
Acknowledgement: We thank the other students in this group, Xinyue Jiang, Dan Luo, Rongyi Wei, and Peilan Li, for their help and support during the sampling process.
Funding Statement: This work was financially supported by the National Natural Science Foundation of China (31960222) and The West Light Talent Program of the Chinese Academy of Science (1–7).
Author Contributions: The authors acknowledge the following contributions to this paper: study conception and design: Wubin Dai; data collection: Xiuting Ju, Guoming Shi; analysis and interpretation of results: Tao He, Jialei Guo; manuscript writing: Wubin Dai, Tao He. All authors reviewed the results and approved the final version of the manuscript.
Availability of Data and Materials: ShCTR1 and ShRBOH1 gene information is available from NCBI (https://www.ncbi.nlm.nih.gov/) under accession numbers ON081649 and OP727799, respectively.
Ethics Approval: Not applicable.
Conflicts of Interest: The authors declare that they have no conflicts of interest to report regarding the present study.
References
1. Katsuhiro S, Hirokazu T, Timothy DC, Mikio N. Role of ethylene in acclimations to promote oxygen transport in roots of plants in waterlogged soils. Plant Sci. 2008;175(1):52–8. doi:10.1016/j.plantsci.2008.03.002. [Google Scholar] [CrossRef]
2. Liu HD, Hao N, Jia YH, Liu XQ, Ni XL, Wang M, et al. The ethylene receptor regulates Typha angustifolia leaf aerenchyma morphogenesis and cell fate. Planta. 2019;250:381–90. doi:10.1007/s00425-019-03177-4. [Google Scholar] [PubMed] [CrossRef]
3. Zhang HY, Wang X, Yan A, Deng J, Xie YP, Liu SY, et al. Evolutionary analysis of respiratory burst oxidase homolog (RBOH) genes in ilants and characterization of ZmRBOHs. Int J Mol Sci. 2023;24(4):3858–8. doi:10.3390/ijms24043858. [Google Scholar] [PubMed] [CrossRef]
4. Yamauchi T, Fukazawa A, Nakazono M. METALLOTHIONEIN genes encoding ROS scavenging enzymes are down-regulated in the root cortex during inducible aerenchyma formation in rice. Plant Signal Behav. 2017;12(11):e1388976. doi:10.1080/15592324.2017.1388976. [Google Scholar] [PubMed] [CrossRef]
5. Trobacher CP. Ethylene and programmed cell death in plants. Botany. 2009;87(8):757–69. doi:10.1139/B09-041. [Google Scholar] [CrossRef]
6. Kawase M. Anatomical and morphological adaption of plants to waterlog-going. Hort Sci. 1981;16:8–12. [Google Scholar]
7. Bleecker AB, Kende H. Ethylene: a gaseous signal molecule in plants. Annu Rev Cell Dev Biol. 2000;16(16):1–18. doi:10.1146/annurev.cellbio.16.1.1. [Google Scholar] [PubMed] [CrossRef]
8. Sun X, Li Y, He W, Ji C, Xia P, Wang Y, et al. Pyrazinamide and derivatives block ethylenebiosynthesis by inhibiting ACC oxidase. Nat Commun. 2017;8(1):15758. doi:10.1038/ncomms15758. [Google Scholar] [PubMed] [CrossRef]
9. Penrose DM, Glick BR. Enzymes that regulate ethylenelevels--1-aminocyclopropane-1-carboxylic acid (ACC) deaminase, ACC synthasend and ACC oxidase. Indian J Exp Biol. 1997;35(1):1–17. doi:10.1105/tpc.3.11.1187. [Google Scholar] [CrossRef]
10. Subbaiah CC, Sachs MM. Molecular and cellular adaptations of maize to flooding stress. Ann Bot. 2003;91(2):119–27. doi:10.1093/aob/mcf210. [Google Scholar] [PubMed] [CrossRef]
11. Drew M, Jackson M, Giffard S. Ethylene-promoted adventitious rooting and development of cortical air spaces in rootsmay be adaptive responses to flooding in Zea mays. Planta. 1979;147(1):83–8. doi:10.1007/BF00384595. [Google Scholar] [PubMed] [CrossRef]
12. Fagerstedt KV. Programmed cell death and aerenchyma formation under hypoxia. Heidelberg. 2010;99–118. doi:10.1007/978-3-642-10305-6_6. [Google Scholar] [CrossRef]
13. Eckhard VR. The genus Saussurea (Compositae, Cardueae) in China: taxonomic and nomenclatural notes. Willdenowia. 2011;41(1):83–95. doi:10.3372/wi.41.41109. [Google Scholar] [CrossRef]
14. Dawa Z, Bai Y, Zhou Y, Gesang S, Ping A, Ding L. Chemical constituents of the whole plants of Saussurea medusa. J Nat Med. 2009;63:327–30. doi:10.1007/s11418-009-0320-1. [Google Scholar] [PubMed] [CrossRef]
15. Wang J, He R, Zhang H, Hu Y, Wang J, Wang L, et al. Complete chloroplast genome of Saussurea inversa (Asteraceae) and phylogenetic analysis. Mitochondrial DNA B Resour. 2021;6(1):8–9. doi:10.1080/23802359.2020.1845108. [Google Scholar] [PubMed] [CrossRef]
16. Dai WB, Shi GM, Ju XT, Li PL, He T. Cloning and expression analysis of Aerenchyma development related ShRBOH1 gene in Saussurea inversa Raab-Straube. Braz J Bot. 2024. doi:10.1007/s40415-024-00999-9. [Google Scholar] [CrossRef]
17. Ni XL, Meng Y, Zheng SS, Liu WZ. Programmed cell death during aerenchymaformation in Typha angustifolia leaves. Aquat Bot. 2014;113(113):8–18. doi:10.1016/j.aquabot.2013.10.004. [Google Scholar] [CrossRef]
18. Zaqout S, Becker LL, Kaindl AM. Immunofluorescence staining of paraffin sections step by step. Front Neuroanat. 2020;14:582218. doi:10.3389/fnana.2020.582218. [Google Scholar] [PubMed] [CrossRef]
19. Clark KL, Larsen PB, Wang XX, Chang C. Association of the Arabidopsis CTR1 Raf-like kinase with the ETR1 and ERS ethylene receptors. P Natl A Sci. 1998;95(9):5401–6. doi:10.1073/pnas.95.9.5401. [Google Scholar] [PubMed] [CrossRef]
20. Kieber JJ. CTR1, a negative regulator of the ethylene response pathway in Arabidopsis, encodes a member of the raf family of protein kinases. Cell. 1993;72(3):427–41. doi:10.1016/0092-8674(93)90119-B. [Google Scholar] [PubMed] [CrossRef]
21. Bie B, Sun J, Pan J, He H, Cai R. Ectopic expression of CsCTR1, a cucumber CTR-like gene, attenuates constitutive ethylene signaling in an Arabidopsis ctr1-1 mutant and expression pattern analysis of CsCTR1 in cucumber (Cucumis sativus). Int J Mol Sci. 2014;15:16331–50. doi:10.3390/ijms150916331. [Google Scholar] [PubMed] [CrossRef]
22. Giordano A, Domingo MS, Quadrana L. CRISPR/Cas9 gene editing uncovers the role of CTR1 and ROS1 in melon fruit ripening and epigenetic regulation. J Exp Bot. 2022;73(12):4022–33. doi:10.1093/jxb/erac148. [Google Scholar] [PubMed] [CrossRef]
23. Jakubowicz M, Nowak W, Gałgański Ł., Babula-Skowrońska D. Expression profiling of CTR1-like and EIN2-like genes in buds and leaves of Populus tremula, and in vitro study of the interaction between their polypeptides. Plant Physiol Biochem. 2019;139:660–71. doi:10.1016/j.plaphy.2019.04.029. [Google Scholar] [PubMed] [CrossRef]
Appendix

Figure A1: Diagram of the results of aerenchyma induction in S. inversa. Scale bar = 50 µm

Figure A2: In situ hybridization results in S. inversa. Scale bar = 50 µm

Figure A3: Diagram of the results of aerenchyma induction in SR tobacco. Scale bar = 50 µm

Figure A4: Diagram of the results of aerenchyma induction in Trans-ShCTR1 tobacco. Scale bar = 50 µm

Figure A5: In situ hybridization results in Trans-ShCTR1 tobacco. Scale bar = 50 µm
Cite This Article
Copyright © 2024 The Author(s). Published by Tech Science Press.This work is licensed under a Creative Commons Attribution 4.0 International License , which permits unrestricted use, distribution, and reproduction in any medium, provided the original work is properly cited.


Submit a Paper
Propose a Special lssue
View Full Text
Download PDF
Downloads
Citation Tools